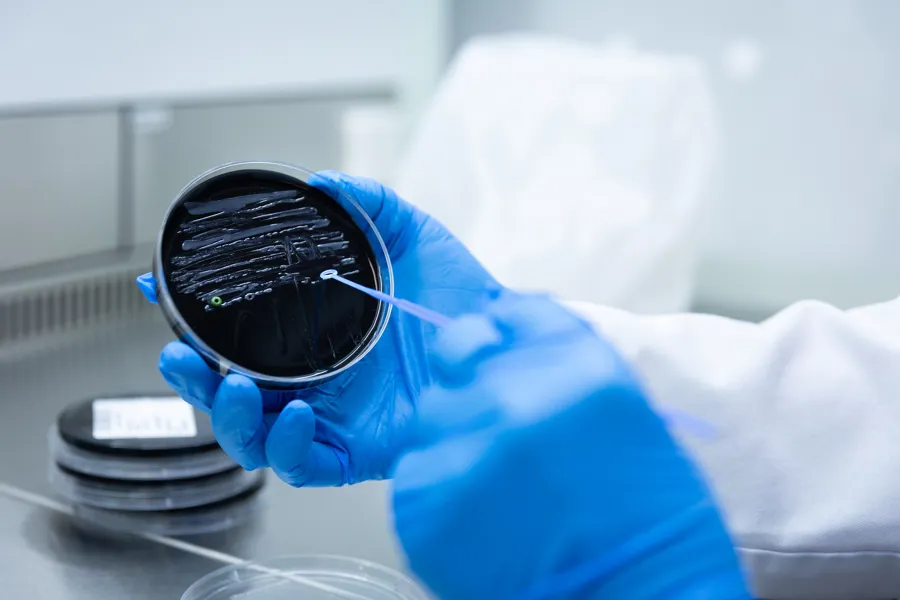

Avdeling for medisinsk mikrobiologi
Vi utfører diagnostikk av infeksjonssykdommer i pasientprøver fra både spesialist- og primærhelsetjenesten. Våre tjenester danner grunnlag for behandling av infeksjoner hos den enkelte pasienten, og for å iverksette smitteverntiltak.
Kontakt
Ekspedisjonen
- Mandag - Fredag 08:00 - 15:30
- Lørdag - Søndag STENGT
Ekspedisjonen vår er stengt alle høytidsdager. For telefonhenvendelser på høytidsdager, ring sykehusets sentralbord 51518000.
Gi oss tilbakemelding
Slik finner du fram
Oppmøtested
SUS Ullandhaug, B-bygget 1. etasje
Sykehusveien 80, 4021 Stavanger
Som nasjonalt referanselaboratorium for Legionella bistår vi med diagnostikk, karakterisering og utbrudds- eller smitteoppklaring.